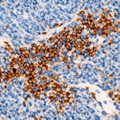

1/19
Looks like no tags are added yet.
Name | Mastery | Learn | Test | Matching | Spaced |
|---|
No study sessions yet.
What is the fundamental difference between Grade and Stage?
Grade is the appearance (how aggressive/abnormal the cells look); Stage is the extent (how far the cancer has physically spread

What does the TNM Staging system stand for?
T (Tumour): Size and local extent of the primary tumour (T1-T4).
N (Nodes): Involvement of regional lymph nodes (N0-N3).
M (Metastasis): Presence of distant spread to other organs (M0 or M1).

What is "Tis" and why is it clinically significant?
Carcinoma in situ. It means cancer cells are present but have not yet crossed the basement membrane. At this stage, the cancer cannot metastasise because it has no access to blood vessels.
What is the difference between Clinical (c) and Pathologic (p) staging?
A: Clinical (c) is based on physical exams and imaging (CT/MRI) before surgery. Pathologic (p) is based on microscopic evidence after a surgeon has removed the tissue.
What are Tumour Markers?
Substances (usually proteins) produced by cancer cells or the body in response to cancer. They are found in blood, urine, or tissue samples.

Name the primary clinical markers for Prostate, Colorectal, and Ovarian cancer.
Prostate: PSA, Colorectal: CEA, Ovarian: CA-125.
Why is PSA considered a "non-specific" marker for screening?
Levels can be raised by non-cancerous conditions such as BPH (enlarged prostate), infection (prostatitis), or even recent exercise/trauma.

What is the difference between "Prognostic" and "Predictive" markers?
Prognostic: Tells you the likely outcome/survival (e.g., "This is a fast-growing cancer").
Predictive: Tells you if a specific drug will work (e.g., "This patient will respond to Herceptin").
What does HER2-positive staining look like on IHC?
Strong, continuous brown rings around the cell membrane.


What does ER (Oestrogen Receptor) positive staining look like?
Strong brown staining strictly within the Nucleus.
Logic: Since ER is a transcription factor, it lives where the DNA is.
What is "Triple Negative" Breast Cancer?
A tumour that lacks Oestrogen Receptor (ER), Progesterone Receptor (PR), and HER2.
How is HER2 used as a Predictive Marker for treatment?
If a patient is HER2 3+ (strong membrane staining), they are eligible for Trastuzumab (Herceptin), which specifically targets that receptor..
What is PD-L1, and why is it called an "Immune Checkpoint"?
PD-L1 is a protein that tumours use to suppress T-cells, thereby hiding cancer from the immune system.
How do you identify a candidate for Immunotherapy (Anti-PD-L1)?
IHC showing brown membrane staining on either the tumour cells or the "Tumour Infiltrating Lymphocytes" (immune cells inside the cancer).
How are markers like CEA used after surgery?
For monitoring. If the marker level drops after surgery but starts rising months later, it is the first sign that the cancer has returned (recurrence).
What is the difference between Histology and IHC?
Histology tells what the cell is; IHC tells what the cell is doing or expressing.

What is the appearance and treatment for Prostate Grade Group 1 (Gleason ≤6)?
Histology (H&E) tells you what the cell is (e.g., Adenocarcinoma); IHC tells you what the cell is doing or expressing (e.g., ER+), which tells the doctor how to kill it.
What is the appearance and treatment for Prostate Grade Group 3 (Gleason 4+3=7)?
Appearance: Mostly fused messy glands; Treatments: External Beam Radiation, Hormone Therapy.

What is the appearance and treatment for Prostate Grade Group 4 (Gleason 8)?
Appearance: Glands are fused or look like sieves; Treatments: Radical Prostatectomy + Lymph Node Removal, Long-term Hormone Therapy.
What is the appearance and treatment for Prostate Grade Group 5 (Gleason 9-10)?
Appearance: Solid sheets of cells with necrosis; Treatments: Docetaxel Chemotherapy, Combination Radiation + High-dose Hormone Therapy.
